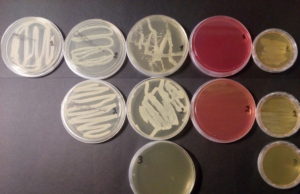

kyritsis education.
Η ιστορία του Μαραθωνίου Δρόμου
Ως "Μαραθώνιος Δρόμος" ορίζεται το αγώνισμα δρόμου μεγάλης αποστάσεως (42.195 χλμ.), που περιλαμβάνεται στο πρόγραμμα των Ολυμπιακών Αγώνων από την πρώτη διοργάνωση το 1896...
Η Ώρα της “Αθλο..Παιδείας”
Πέμπτη 08 Μαρτίου, και όπως κάθε Πέμπτη η ραδιοφωνική παρέα, χορηγούμενη από το Φροντιστήριο "Κυρίτσης" μάς κρατά μια ώρα συντροφιά με θέματα Παιδείας.
Αυτή τη...
Δημόσιο Πανεπιστήμιο Κύπρου
Το Πανεπιστήμιο Κύπρου είναι Νομικό Πρόσωπο Δημοσίου Δικαίου και διοικείται από το Συμβούλιο, το οποίο «έχει τη διαχείριση και έλεγχο των διοικητικών και οικονομικών...
Η παιδεία μας στον επαγγελματικό προσανατολισμό από την «ΩΡΑ της ΠΑΙΔΕΙΑΣ»...
Η βαρύτητα του θέματος "Επαγγελματικός Προσανατολισμός" είναι μεγάλη για την εκπαιδευτική ομάδα του "Φροντιστηρίου Κυρίτσης". Συνεπώς και το ενδιαφέρον μας ακόμα μεγαλύτερο, τόσο που...
Ποιοι δικαιούνται μετεγγραφή
Εκδόθηκε στις 05/03/2018, η υπουργική απόφαση σχετικά με τη μετεγγραφή αδελφών, προπτυχιακών φοιτητών ΑΕΙ, που σπουδάζουν σε διαφορετική Περιφερειακή Ενότητα τόσο μεταξύ τους όσο...
Πείραμα Βιολογίας&Χημείας, 03/03/2018
Στο πλαίσιο της προσπάθειας μας να είμαστε δίπλα στους μαθητές μας κάνοντας τους να κατανοούν το μάθημα όσο το δυνατόν περισσότερο, διοργανώνουμε συχνά πειράματα...
Πανελλήνιες 2018: Πότε ξεκινούν εξετάσεις και δηλώσεις συμμετοχής
Στις 6 Ιουνίου 2018 θα αρχίσουν οι φετινές Πανελλήνιες εξετάσεις στα Γενικά Λύκεια για την εισαγωγή των υποψηφίων στα ανώτατα ιδρύματα της χώρας.
Στα επαγγελματικά...
Ημερίδα Επαγγελματικού Προσανατολισμού 04/03/2018
Μια όμορφη ανοιξιάτικη Κυριακή, την 04/03/2018, επέλεξε το "Φροντιστήριο Κυρίτσης" να διοργανώσει μια ημέρα σταδιοδρομίας με πρωταγωνιστές τους μαθητές του Λυκείου, στο κέντρο της...
“ΛΥΣΙΑΣ 2018” – Πανελλήνιος Μαθητικός Διαγωνισμός μέσω Internet
Ο Λυσί@ς είναι Πανελλήνιος Μαθητικός Διαγωνισμός μέσω Internet, ο οποίος οργανώνεται για 22η συνεχή χρονιά.
Ο διαγωνισμός διεξάγεται, παραδοσιακά υπό την αιγίδα του Υπουργείου Παιδείας, Έρευνας και Θρησκευμάτων, από τα Εκπαιδευτήρια Δούκα,...
Με e-mail η ενημέρωση των γονέων για τις απουσίες των μαθητών
Έτοιμη η «πλατφόρμα» για την ηλεκτρονική αποστολή των ειδοποιητηρίων στους κηδεμόνες των μαθητών – Το επόμενο διάστημα το σύστημα θα επεκταθεί με προσωποποιημένα μηνύματα...